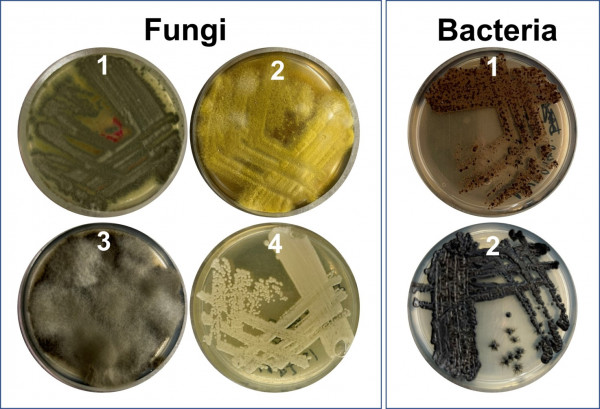

Helen Woolner

2024: Dr Helen Woolner of Te Herenga Waka Victoria University of Wellington has been awarded a New Zealand Mana Tūānuku Research Leader Fellowship. Combining Pacific Island knowledge with an all-encompassing scientific approach, Dr Woolner will investigate the potential of marine organisms to provide a new generation of antibiotic drugs
Dr Woolner received a PhD in Chemistry in 2017 from Victoria University of Wellington. In 2018, she was awarded a Pacific Health Research Postdoctoral Fellowship by the Health Research Council of New Zealand. She was appointed as Lecturer at Victoria University of Wellington in 2022. She won the Zonta Biennial Science Award in 2020. Dr Woolner held a position as a Leadership Group member at the Centre for Biodiscovery at Victoria University of Wellington from 2022 to 2024 and as Associate Investigator at the Centre for Research Excellence (CoRE) Maurice Wilkins for Molecular Biodiscovery. Dr Woolner collaborates extensively with international and domestic researchers, holders of Indigenous knowledge, and Māori and Pacific research groups and is a member of the Te Vairanga Kite Pakari Cook Islands Research Association. Recently, she has discovered a new antibiotic as well as a key bioactive compound in a traditional Samoan medicinal plant used to treat inflammation.
Development of antibiotic drugs by pharmaceutical companies is falling behind the rising threat of antimicrobial resistance of disease-causing bacteria. This is leading to an escalating medical crisis where we lack effective treatments for serious and potentially life-threatening infections. As a result, the search for novel antimicrobial substances must turn to new sources, such as the marine environment. Working with holders of Pacific Indigenous knowledge, Dr Woolner will collect promising marine organisms from the Cook Islands and Samoa to discover natural chemicals with antimicrobial activity that are harboured within marine fungi and bacteria. She will bring together Pacific Indigenous wisdom with the full range of genetic and biochemical analyses to identify antimicrobial compounds with promise as new antibiotic drug candidates.
Four different types of marine fungi and two types of marine bacteria found in sea sponges that are being studied for new antimicrobials (Supplied)
